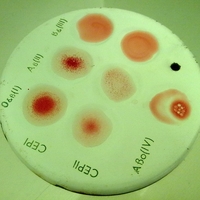
Обнаружен новый фактор риска сердечно-сосудистых заболеваний

Уважаемые коллеги! Приглашаем Вас и Ваших коллег принять участие в 4-й
В НИИ СП им. Н.В. Склифосовского провели пересадку легких пациентке с муковисцидозом. Программа трансплантации легких, успешно стартовавшая в НИИ СП им. Н.В. Склифосовского в прошлом году, п
Watch the INTRABEAM IORT Procedure for Breast Cancer
найти-врача.рф это рекомендательный сервис по выбору врача и медучреждений, первый в России.
Выберите свой город, например, Москва.
На сайте необходимый специалист ответит на Ваш вопрос онлайн, даст совет и осуществит запись на прием для проведения консультации, так же можете узнать возможен ли вызов на дом. После того как врач проведет осмотр, либо вы посетите медучреждения из каталога найти-врача.рф, обязательно оставьте свои отзывы, помогите сделать выбор другим.
Вы можете найти адреса и телефоны интересующих Вас медучреждений.
Поиск врача и мед учреждения - большая и ответственная работа, в которой найти-врача.рф станет Вашим первым помощником.
Врач же может найти на сайте найти-врача.рф признание пациентов и список вакансий.
Новости
Обнаружен новый фактор риска сердечно-сосудистых заболеваний
Определение группы крови расскажет о риске развития сердечно-сосудистых заболеваний. Вторая, третья и четвертая группа крови несут больший риск развития заболеваний сердца и сосудов, в сравнении с первой группой крови. Результаты исследования американских ученых представлены в статье, опубликованной в научном журнале Arteriosclerosis, Thrombosis and Vascular Biology.
В опубликованном пресс-релизе Американской кардиологической ассоциации сообщается о распространенности среди населения 4 групп крови и выявленном риске развития заболеваний сердца. Самая редкая группа крови AB (известна как «четвертая» группа крови) сопряжена с максимальным риском сердечно-сосудистых заболеваний: он составляет для носителей данной группы крови 23%. У людей с «третьей» группой крови (группой крови В) риск значительно меньше, 11%. В группе с А группой крови («второй» группой) риск сердечно-сосудистых заболеваний еще ниже, 5%. Риск у людей с 0 группой крови («первой» группой) наименьший в отношении развития патологий сердца и сосудов.
Ученые подчеркивают, что данные выводы не означают отсутствия развития заболеваний у людей с первой группой крови. Риск заболевания остается, однако на значительно меньшем уровне.
Доктор Лу Ки, профессор кафедры питания Гарвардского факультета здравоохранения, считает, что открытие ученых позволит «лучше понимать» группу риска развития возможных сердечно-сосудистых заболеваний. По мнению доктора Лу, факторы, связанные с определенной группой крови, оказывают многостороннее действие на организм человека. Знание своей группы крови станет также важным, как контроль уровня артериального давления и содержания холестерина в крови.
Можно ли доверять выводам ученых? Как известно, американская система здравоохранения основана на данных доказательной медицины. Группа ученых из Гарвардского факультета здравоохранения провели научную работу с обзором 2 крупных исследований по состоянию здоровья населения США. Ученые собрали данные о 90.000 американцев в возрасте 30-75 лет. Обзор данных о состоянии их здоровья продолжался на протяжении 20 лет.
Ученые учитывали такие известные факторы риска, как особенности питания, индекс массы тела, пол, этнос, табакокурение, перенесенные заболевания. Впервые ученые проанализировали состояние здоровья с учетом группы крови исследуемых.
Результаты исследования позволили ученым прийти к заключению о высокой частоте дислипидемии у людей со второй группой крови (группой А): при наличии данной группы крови был обнаружен повышенный уровень липопротеинов – соединений холестерина. Липидный спектр крови был значительно изменен. Дислипидемия приводит к развитию атеросклероза – системного процесса, который характеризуется нарушением кровоснабжения внутренних органов за счет появления атеросклеротических бляшек. В частности по подобной схеме развивается ишемическая болезнь сердца и ее формы: инфаркт миокарда, сердечные приступы или сердечная недостаточность.
У людей с четвертой группой крови чаще наблюдали воспалительные заболевания, которые также способствуют появлению и развитию атеросклероза и связанных с ним опасных заболеваний.
При наличии первой группы крови, выше уровень веществ, благоприятно воздействующих на систему свертывания крови и кровоток.
Мнение найти-врача.рф: Современная медицина учитывает факторы риска, которые могут быть модифицируемыми (изменяемыми) и немодифицируемыми. Естественно, человек может отказаться от курения, приема алкоголя, изменить свое питание и образ жизни. В то же время, пол, национальность и возраст изменить невозможно. Благодаря открытию ученых, список немодифицируемых факторов пополнился новым – группой крови. Зачем же нужны факторы, которые все равно ни врач, ни пациент не смогут изменить? Зная о своем риске развития заболеваний, появляется возможность повлиять на возможное развитие болезней, для этого потребуется изменить привычный уклад жизни: отказаться от питания с повышенным содержанием холестерина и высоким содержанием углеводов, вести здоровый образ жизни и физическую активность, всегда помнить о консультации со специалистами. найти-врача.рф поможет найти медицинское учреждение и специалиста, который ответит на все Ваши вопросы.
Есть мысли на тему новости? Поделитесь!
Другие новости
Исследование с участием 2 тысяч испытуемых проведено в 18 клиниках ЕС. Выявлена зависимость между концентрацией витамина D и риском развития
Бактерии регулируют гематоэнцефалический барьер в головном мозге, развитие моторных функций и чувства страха
Паразитирующий в речной рыбе печеночный сосальщик вызывает развитие рака печени. Ученые из Института цитологии и генетики Российской академии наук
Американские исследователи изучили воздействие статинов на организм человека, в зависимости от наличия факторов риска сахарного диабета
Исследователи из Вашингтонского университета выявили ген CARD14. Мутации в данном гене приводят к развитию вульгарного псориаза